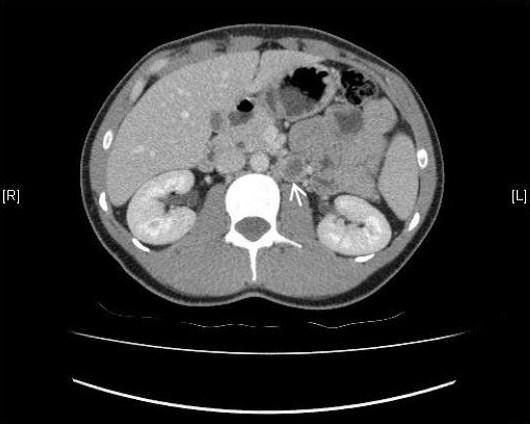

|

|
 |
|
Case Report
| ||||||
| Rare sequelae of a testicular tumor: A 'burnt-out' tumor | ||||||
| Francesca Kum1, Faisal Ghumman2, Matin Sheriff3 | ||||||
|
1MBBS, BSc, Foundation Year 2 Doctor, Department of Urology, Medway Maritime Hospital, UK.
2FRCS(Urol), FCPS(Pak), Urology Specialist Registrar, Department of Urology, Medway Maritime Hospital, UK. 3PhD, FRCS, FRCS(Urol), FEBU, Consultant Urological Surgeon, Department of Urology, Medway Maritime Hospital, Canterbury and Christ Church University, UK. | ||||||
| ||||||
|
[HTML Abstract]
[PDF Full Text]
[Print This Article]
[Similar article in Pumed] [Similar article in Google Scholar] 
|
| How to cite this article |
| Kum F, Ghumman F, Sheriff M. Rare sequelae of a testicular tumor: A 'burnt-out' tumor. Int J Case Rep Images 2015;6(1):16–20. |
|
Abstract
|
|
Introduction:
Testicular tumors typically present as a palpable lump. Some tumors have been known to spontaneously regress, thus have been referred to as 'burnt-out' tumors or vanishing tumors.
Case Report: A 28-year-old male was seen in urology clinic with clinical findings of a small atrophic left testis, with a prior history of a painful left testicular lump not responsive to antibiotics, which had spontaneously resolved. Ultrasound scan revealed an initial solid testicular lesion of 19x12x10 mm with internal vascularity, which upon repeat ultrasound scan two months later found a 12-mm coarse calcification and a hypoechoic region, but regression of the initial solid lesion. The diagnosis of a burnt-out tumor was made and he underwent urgent radical orchidectomy and prosthesis insertion. Computed tomoraphy (CT) staging scan showed significant paraortic lymphadenopathy, therefore the patient further underwent chemotherapy. Treatment has been successful and the patient is progressing well with no complications. Conclusion: The diagnosis of a burnt-out testicular tumor is an important differential to consider in patients with spontaneously regressing testicular lumps, abnormal findings on ultrasound scan and subsequent presentation of testicular atrophy of unknown cause. This diagnosis should also be considered in patients with secondary metastatic tumors of unknown primary. | |
|
Keywords:
Burnt-out tumor, Cancer, Fast-track (2-week-wait) referral, Orchidectomy, Self-resolving tumor, Testicular cancer, Testicular tumor, Vanishing tumor
| |
|
Introduction
| ||||||
|
Testicular cancer primarily affects younger men typically aged 20–55 years. Presence of a testicular lump is an indication for referral to urology under the fast-track cancer pathway as an estimated 97% of testicular cancers present with a palpable mass [1]. Some tumors have exhibited the ability to spontaneously regress in size, thus presenting as an occult primary tumor. The diagnostic workup and management of these 'burnt-out' or vanishing tumors is identical to that of a typical testicular lump. This article presents a case of a burnt-out tumor, the important characteristic radiological findings and subsequent management. | ||||||
|
Case Report
| ||||||
|
A 28-year-old male presented via the fast-track cancer pathway to urology clinic with a preceding history of a new onset left sided testicular pain and swelling. His general physician initially prescribed antibiotics for suspected epididymitis, but there was poor response over the ensuing weeks. An ultrasound scan was also requested and performed shortly after his first presentation (Figure 1). However, the report was not reviewed until the point when he was referred to urology two months later. This initial ultrasound scan reported a well-defined solid lesion in the lower pole of the left testis, measuring 19x12x10 mm with a calcific area and internal vascularity noted (Figure 1). The right testis was normal, as were both epididymis. A right sided varicocele was also noted. At this point, a fast-track 2-week-wait referral to urology as 'swelling in body of testicle suspicious of cancer' was made. When seen in urology outpatient clinic, the left testis was found to be notably smaller than his right testis with a small palpable solid component in the lower pole. Subsequent testicular ultrasound (Figure 2) was performed some two months after the initial one and documented changes in the left testis from previous ultrasound scan with a few micro-calcification foci, coarse calcification of 12 mm length and an adjacent smaller low echoic area measuring 8x7 mm. The right testis was again normal. The report concluded a hypoechoic area in left testis adjacent to coarse calcification of which a burnt-out tumor should be excluded. The patient was counseled and he decided not to take the risk of possible future tumor spread, therefore underwent left radical orchidectomy and insertion of prosthesis three days after being seen in urology clinic. Macroscopically the left testis sample was 5x3x2.5 cm + epididymis + 5 cm cord attached. A poorly circumscribed greyish-white matter was noted within the testis, measuring 0.8 cm in diameter, which is a significantly smaller volume compared to the initial ultrasound scan, thus highly indicative of spontaneous reduction in tumor size without intervention. Upon microscopic examination the tumor type was a malignant teratoma with a cell composition of 60% embryonal carcinoma and 40% choriocarcinoma. The presence of background intratubular germ cell neoplasia, the precursor cell type to neoplasia, was noted in the surrounding testicular tissue. The tumor was confined to the testis, but vascular invasion was present. Histopathology of concluded a pT2 staging and β-hCG was elevated at 5172, thus correlating with that of a teratoma. After orchidectomy, computed tomography scan of chest, abdomen, and pelvis with contrast was performed to assess for lymphatic involvement or metastatic spread (Figure 3). Computed tomography (CT) scan showed evidence of left para-aortic lymph node enlargement 22x21 mm with a necrotic centre. A few small volume lymph nodes were also noted adjacent to this enlarged necrotic node. There was no evidence of lung, liver or bony metastasis or lymphadenopathy and bony windows were unremarkable. The patient was treated with adjuvant chemotherapy (BEP - bleomycin etoposide cisplatin) under the care of a tertiary Urology cancer centre. Shortly after his second cycle, he presented with a dry cough, coryzal symptoms, headache, tachycardia and pyrexia of 39.1oc. He was successfully treated with Tazocin and GCSF (granulocyte colony stimulating factor) for neutropenic sepsis. The patient has subsequently completed chemotherapy and is progressing well. | ||||||
| ||||||
| ||||||
|
| ||||||
|
Discussion
| ||||||
|
This study presents a case of mixed cell type testicular teratoma with para-aortic spread, in which the primary neoplasm had spontaneously regressed within the two-month interval between ultrasound assessments. Testicular cancer usually presents with a palpable testicular lump in 97% of cases [1]. In contrast, clinical findings of burnt-out tumors on examination are often occult, such as an apparently normal sized testicle; or an atrophic testis, which develops insidiously; or an incidental finding of a retroperitoneal mass on imaging [2]. In such cases, it is essential that investigation and further imaging of the inguinoscrotal area should be performed to search for the tumor source. Primary extragonadal germ cell tumors are rare and account for 5–10% of all germ cell tumors [3]. It is estimated that of the apparently primary extragonadal germ cell tumors, 10% are in fact due to underlying burnt-out testicular neoplasms [4]. In recent literature, these testicular tumors have also been described as 'vanishing' or 'self-resolving' tumors. However, although the initial testicular lesion may spontaneously regress, this does not negate the metastatic potential from the primary neoplasm to para-aortic and retroperitoneal lymph nodes and surrounding structures [2]. Existing literature reports specific ultrasound and histopathological findings which are indicative of previous presence of a testicular tumor [3] [5] [6]. Primary testicular tumors typically appear as a hypoechoic area on ultrasound. In the case of burnt-out tumors, some hypoechoic tumor tissue usually persists, in addition to histological findings of fibrous scar tissue with hemosiderin deposition, clustered macrocalcification or microcalcification, microlithiasis and increased hematoxyphilic bodies [5] [6]. Intratubular malignant germ cells and calcifications may also be present relating to Sertoli cells. Computed tomography scan remains the gold standard for assessing, staging lesions and metastases and guiding management plans after initial ultrasound reveals a testicular abnormality. The underlying pathophysiology of tumor involution thus leading to the 'burning out' remains a topic of postulation [7] [8] [9]. It is thought that the initial aggressive nature of tumor growth eventually exceeds its vascular supply, thus resulting in subsequent death and spontaneous regression. Immunological theories are also considered such that cell-mediated immunity and recognition of tumor antigens may contribute to tumor destruction. Such autoimmune theories have previously been established in the response to in situ carcinoma of the testis. The pathway of cancer referrals from primary to secondary specialist care is another current topic. It is widely known that delay in assessment adversely affects disease progression and patient outcome, therefore the National Health Services (NHS) two-week-wait referral system endeavors to ensure this [10]. The estimated incidence of testicular cancer in England is 7.3% with one-year survival rates of 98%. The criteria for activating this urgent referral pathway is the presence of a swelling or mass in the testicle. The National Institute for Health and Care Excellence (NICE) further recommends that the general physician should consider requesting an ultrasound scan if the lump cannot be distinguished from the testicular body itself. As with many other cases, imaging and further investigations are required, but these should not delay referral to specialist services [11]. Furthermore, this case illustrates the need for efficient review of investigation results by general physician and prompt of these suspected cancer cases to ensure better patient outcome. | ||||||
|
Conclusion
| ||||||
|
In summary, this case report highlights the importance of early referral and subsequent management of a testicular cancer case. Early ultrasound scan is essential in the investigation of any testicular lump. Burnt-out testicular tumors are an important differential to consider in patients with spontaneously regressing testicular lumps, and subsequent presentation of testicular atrophy of unknown cause. This diagnosis should also be considered in patients with secondary metastatic tumors of unknown primary. Prompt surgical management of orchidectomy is usually required and subsequent computed tomography scan for disease staging and grading. | ||||||
|
References
| ||||||
| ||||||
|
[HTML Abstract]
[PDF Full Text]
|
|
Author Contributions
Francesca Kum – Substantial contributions to conception and design, Acquisition of data, Analysis and interpretation of data, Drafting the article, Revising it critically for important intellectual content, Final approval of the version to be published Faisal Ghumman – Substantial contributions to conception and design, Acquisition of data, Analysis and interpretation of data, Revising it critically for important intellectual content, Final approval of the version to be published Matin Sheriff – Substantial contributions to conception and design, Revising it critically for important intellectual content, Final approval of the version to be published |
|
Guarantor of submission
The corresponding author is the guarantor of submission. |
|
Source of support
None |
|
Conflict of interest
Authors declare no conflict of interest. |
|
Copyright
© 2015 Francesca Kum et al. This article is distributed under the terms of Creative Commons Attribution License which permits unrestricted use, distribution and reproduction in any medium provided the original author(s) and original publisher are properly credited. Please see the copyright policy on the journal website for more information. |
|
|
|
About The Authors
| |||
| |||
| |||
| |||